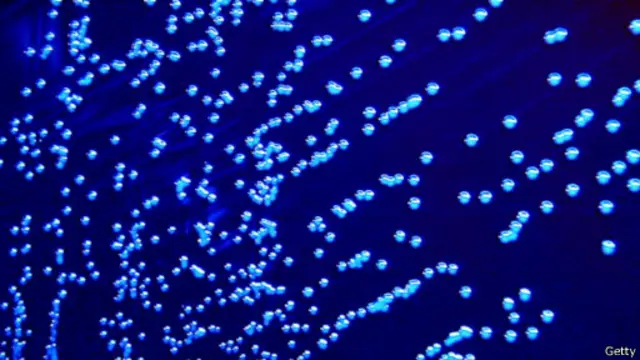
布魯氏菌

加拿大專家承認向中國偷運危險細菌
圖像來源,Getty
中國官方通訊社新華社報道,加拿大食品檢驗局前首席研究員、加拿大傳染病學家克勞斯·尼爾森承認企圖將危險細菌走私到中國。
報道說,渥太華高等法院周五(8月15日)對該案進行答辯,尼爾森承認企圖將加拿大食品檢驗局財產商業化、不安全運輸危險品等11項罪名。
報道說,2013年4月,加拿大皇家騎警公布,尼爾森和身為同事的華裔妻子於偉玲於2010年10月在渥太華機場凖備飛往中國時被警方截住。
警方在尼爾森的行李中搜出17個裝有病原體的小藥瓶和一些山羊血,後證實小藥瓶內裝的是活的布魯氏桿菌。
加拿大警方隨後對同案嫌疑人於偉玲展開全國通緝。警方表示,早在2005年9月就開始注意到這兩個人。
布魯氏桿菌可寄宿在動物身上,人類通常通過接觸受感染動物的分泌物,或進食受污染的肉類或奶製品而遭感染,人與人之間的傳染較罕見。
美國將布魯氏桿菌視為一種「生物恐怖主義」威脅。
報道說,現年68歲的尼爾森目前處於保釋狀態。渥太華法庭預計今年晚些時候才會宣判,這些罪名最高可判有期徒刑10年。
(綜合/責編:高毅)








